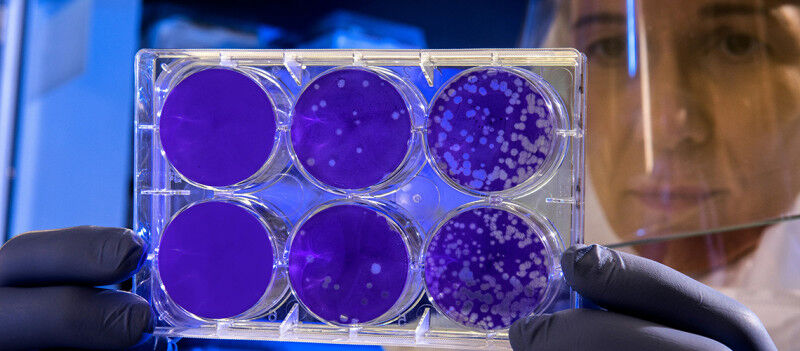

A team from the University of Geneva has shown that certain antibodies to seasonal flu can also target avian flu. Stimulating these antibodies could strengthen protection in the event of a pandemic.
Are seasonal flu antibodies also effective against avian flu? A team from the University of Geneva has shown that a specific type of antibody associated with the former virus-already present throughout the population-may offer baseline protection against the latter. However, the level of protection varies depending on age and vaccination history. Published in Nature Communications , these findings provide valuable insights for anticipating a potential avian influenza pandemic.
Circulating in many regions of the world - including Switzerland - the avian influenza A(H5N1) virus spreads primarily among birds. Recently, however, several cases of transmission to cattle and subsequently to humans have been reported in North America ( 71 cases in the United States), reigniting concerns about the risk of a future pandemic. A variant belonging to a specific evolutionary lineage - clade 2.3.4.4b - is drawing particular attention from epidemiologists because of its high virulence.
Several studies have shown that pre-existing immunity to seasonal human influenza viruses can influence the severity of H5N1 infection. "We have all been exposed to human influenza viruses and therefore carry antibodies against them, many of which share a common genetic basis with H5N1. Some of these antibodies - known as cross-reactive antibodies - are able to recognise H5N1 and, to some extent, help fight it," explains Benjamin Meyer, research associate at the Centre of Vaccinology in the Department of Pathology and Immunology at the University of Geneva Faculty of Medicine.
People who were vaccinated in 2009 during the H1N1 influenza pandemic - with a vaccine containing an adjuvant designed to boost the immune response - show an increase in cross-reactive antibodies.
Vaccinated in 2009? Higher antibody levels
Thanks to recent work, Benjamin Meyer and his team have shown that these cross-reactive antibodies target mainly the "stem" of the virus - the part it shares with seasonal flu - rather than its frequently changing "head." Even more importantly, the researchers discovered that, unlike other antibodies, these ones do not prevent the H5N1 virus from entering cells. Instead, they block its ability to spread from one cell to the next. After replicating inside a host cell, the virus detaches itself but remains anchored to the cell membrane. To break free and continue its infection cycle, it relies on a protein that functions like molecular scissors. It is this cutting mechanism that cross-reactive antibodies inhibit, with varying degrees of effectiveness from one individual to another.
By examining these individual differences, scientists have uncovered another important finding: people who were vaccinated in 2009 during the H1N1 influenza pandemic - with a vaccine containing an adjuvant designed to boost the immune response - show an increase in cross-reactive antibodies capable of effectively neutralising the H5N1 virus. In contrast, no increase in cross-reactive antibodies was detected in individuals who received a standard seasonal flu vaccine. This strengthened immune response may be associated with milder symptoms in the event of avian influenza infection.
The year of birth also matters
"Our study also shows that early-life exposure matters: people born before 1965 - who were exposed in childhood to seasonal influenza viruses of the H1 or H2 subtypes - naturally have higher levels of antibodies against H5N1. In contrast those born later were exposed to different seasonal flu subtypes and have lower baseline protection," explains Mariana Alcocer Bonifaz, a doctoral candidate at the Centre of Vaccinology in the Department of Pathology and Immunology at the University of Geneva Faculty of Medicine, and first author of the publication.
These findings underscore the importance of adjuvanted influenza vaccination in broadening immune responses against the threat of an avian influenza pandemic. Such a strategy would also offer a major advantage in the event of a pandemic: the amount of H5N1 vaccine - already available - required per person would be much lower compared to non-adjuvanted influenza vaccination, thereby increasing overall vaccination capacity for the same level of production.



